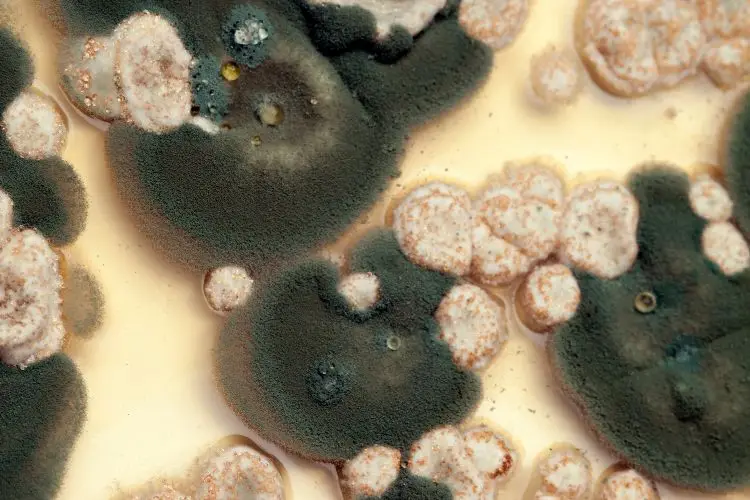

Ihr Zuhause ist ein Ort des Komforts und der Geborgenheit, doch bei zu hoher Feuchtigkeit hinter den Wänden verbirgt sich eine unsichtbare Gefahr – Schimmel. In diesem Blogbeitrag beleuchten wir die verschiedenen Schimmelarten und ihre Auswirkungen auf Gesundheit und Inventar.
Schwarz
Die am häufigsten vorkommende Farbe von Schimmelpilzen ist Schwarz. Schwarzer Schimmel ist oft ein Anzeichen für Feuchtigkeitsschäden und kann gesundheitsschädlich sein. Bekannte Arten von schwarzem Schimmel sind Aspergillus niger und Cladosporium sphaerospermum.
Wenn Sie schwarzen Schimmel in Ihrem Zuhause entdecken, sollten Sie unverzüglich Massnahmen ergreifen, da er ernsthafte Gesundheitsprobleme verursachen kann.

Grün
Grüner Schimmel ist eine weitere häufig vorkommende Schimmelart. Die Sporenträger dieses Schimmels zeigen eine grünliche Färbung, während die übrigen Teile eher in Grau- oder Weisstönen erscheinen. Aspergillus fumigatus ist weitverbreitet und findet sich oft auf Lebensmitteln und in Blumenerde, aber auch an feuchten Wänden und Decken. Aufgrund seiner Sporen kann er sich leicht in der gesamten Wohnung verbreiten. Besonders gefährdet sind Feuchträume wie das Badezimmer und die Küche, Fugen sowie schlecht belüftete Bereiche wie unter dem Fussbodenbelag oder hinter Wandverkleidungen.

Der grüne Schimmel kann unterschiedliche Texturen annehmen, neigt jedoch dazu, einen flauschigen Belag zu bilden. Es ist nicht ungewöhnlich, dass er zusammen mit anderen Schimmelarten auftritt und so eine vielfältige Mischung bildet. Obwohl grüner Schimmel im Allgemeinen weniger gesundheitsschädlich ist als schwarzer Schimmel, kann er dennoch Allergien oder Atemwegserkrankungen auslösen.
Weiss
Weisser Schimmel bleibt oft unbemerkt, da er auf helleren Oberflächen wie Putz oder hellen Wandfarben schlecht erkennbar ist und daher unauffällig wirkt. Dies ermöglicht ihm, sich ungehindert auszubreiten, ohne frühzeitig erkannt zu werden. Erst nach einer gewissen Zeit beginnt weisser Schimmel sich zu verfärben und nimmt eine dunklere Erscheinung an.

Weisser Schimmel tritt häufig an Decken- oder Fussbodenecken, in versteckten Nischen, hinter Möbeln an Aussenwänden und in kühlen, unbeheizten und feuchten Räumen auf. Anzeichen für weissen Schimmel können ein leicht modriger Geruch oder das Auftreten von Kellerasseln, Silberfischchen oder Staubläusen in der Wohnung sein, da diese auf eine feuchte Umgebung hindeuten. Weisser Schimmel kann die Schleimhäute reizen und bei den Bewohnern Symptome wie Nasennebenhöhlenentzündungen, häufige Erkältungen, Hautprobleme, Halsreizungen, Husten, chronische Bronchitis oder Gelenkschmerzen verursachen. Diese Warnsignale werden jedoch oft fälschlicherweise der trockenen Raumluft zugeschrieben. Wenn dann die Luft zusätzlich befeuchtet wird, schafft dies noch bessere Wachstumsbedingungen für den weissen Schimmel als zuvor.
Gelb
Der gelbe Schimmel, auch bekannt als «Aspergillus flavus», wird in Wohnräumen aufgrund seines weniger auffälligen Erscheinungsbildes oft weniger stark wahrgenommen als der grüne oder schwarze Schimmel. Dennoch kann er sich auch in Wohnbereichen ansiedeln. Gelber Schimmel präsentiert sich in Innenräumen eher selten in einem leuchtenden Gelb, sondern tendiert eher zu Ocker- oder Braunnuancen. In der Schweiz ist er aufgrund der hohen Hygienestandards selten anzutreffen.

Dieser Schimmelpilz kann im Grunde an denselben Stellen wie andere Schimmelarten auftreten, jedoch bevorzugt er feuchte Ecken, Baumwollstoffe und Polstermöbel. Seine Konsistenz kann von trocken über flockig, körnig bis schmierig variieren.
Der gelbe Schimmel gibt während seines Stoffwechsels das schädliche Aflatoxin an seine Umgebung ab, ähnlich wie der schwarze Schimmel. Aflatoxin kann beim Menschen verschiedene gesundheitliche Probleme verursachen, darunter Leberkrebs und Herzversagen.
Rot
Roter Schimmel, auch als «Neurospora» oder «Chrysonilia sitophila» bekannt, wächst am besten in Bereichen, die viel Zellulose enthalten. Er ist oft als «roter Brotschimmel» oder «Bäckerschimmel» bezeichnet und findet sich häufig auf Getreide, Mehl und in Bäckereien. Man findet den Schimmelpilz häufiger in Badezimmern, Toiletten und Küchen, da die Bedingungen dort für sein Wachstum besser geeignet sind als in anderen Wohnbereichen.

Die Schimmelablagerungen können eine Bandbreite von Rottönen und Farbintensitäten aufweisen und variieren in ihrer Konsistenz von eher trocken bis schleimig. Es ist wichtig zu beachten, dass der rote Schimmel gesundheitliche Probleme verursachen kann, insbesondere Atemwegsprobleme wie Asthma, wenn er eingeatmet wird.
ecoQ DryAir 13L CompleteIdeal für das Badezimmer.Mehr erfahrenecodry NeptunLeistungsstarker Kellerentfeuchter und leistungsstarker Wäschetrockner.Hier klickenecoQ DryAir 25L Complete Ideal zum energiesparenden Entfeuchten, Reinigen der Luft und Trocknen von Wäsche in der Wohnung.Hier klickenecodry CaveMasterDer leistungsstarke Luftentfeuchter ist 70 % effizienter als Geräte der Energieeffizienzklasse A.Hier klicken
Wie kann ich den Schimmel entfernen?
Wenn Sie Schimmel in Ihrem Zuhause entdecken, ist es ratsam, ihn so schnell wie möglich zu entfernen. Schimmel kann nicht nur gesundheitsschädlich sein, sondern auch Schäden an der Bausubstanz und den Möbeln verursachen. Hier sind die Schritte zur Entfernung von Schimmel:
- Tragen Sie Schutzkleidung wie Handschuhe, eine Maske und eine Schutzbrille.
- Entfernen Sie den sichtbaren Schimmel mit einem Spachtel oder einem Messer.
- Reinigen Sie die betroffene Oberfläche mit einem Desinfektionsmittel.
- Trocknen Sie die betroffene Oberfläche vollständig.
- Wenn der Schimmelbefall grossflächig ist oder sich an schwer zugänglichen Stellen befindet, sollten Sie einen Fachmann hinzuziehen, um sicherzustellen, dass der Schimmel vollständig entfernt wird.
Wie kann ich Schimmelbildung vermeiden?
Stellen Sie sicher, dass Ihr Zuhause ausreichend belüftet ist, um Feuchtigkeitsansammlungen zu verhindern. Ein effizienter Weg, dies zu erreichen, ist die Verwendung eines starken Luftentfeuchters. Ein solches Gerät kann dabei helfen, die Luftfeuchtigkeit in Ihrem Zuhause auf das empfohlene Niveau von 40 % bis 60 % zu halten, idealerweise bei 55 %. Regelmässiges Lüften ist ebenfalls wichtig, um frische Luft hereinzulassen und die Feuchtigkeit zu kontrollieren.
Bitte denken Sie daran, regelmässig Wände, Decken und Böden auf Anzeichen von Schimmelbildung zu überprüfen und Feuchtigkeitsquellen zu beseitigen. Mit einem Luftentfeuchter und sorgfältiger Beobachtung können Sie dazu beitragen, ein gesundes und angenehmes Raumklima in Ihrem Zuhause aufrechtzuerhalten.